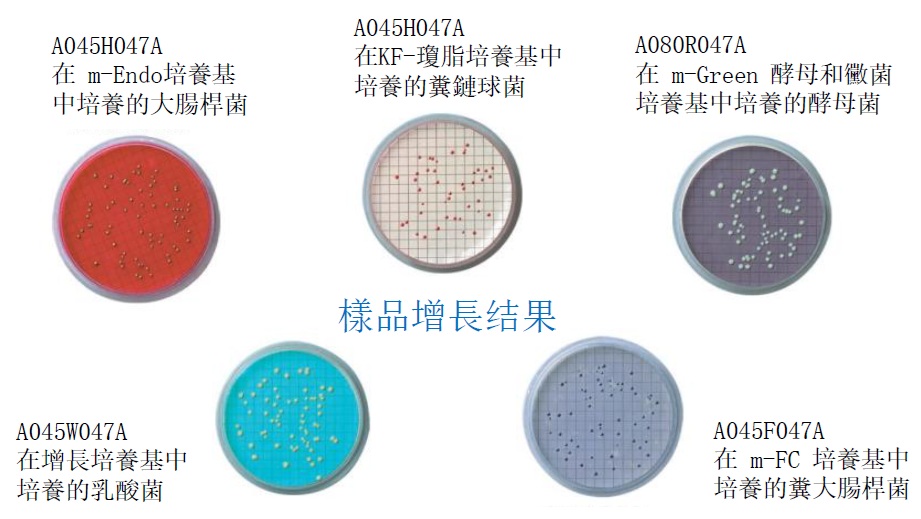

微生物學用濾膜介紹
材質組成:
混合纖維素酯(MCE):由硝化纖維素與其他纖維素酯混合製成。
醋酸纖維素:也可作為另一種濾膜材質供選擇。
產品特點:
1. 格線設計:
* 濾膜可提供對比明顯的格線,有助於準確計數菌落。
* 格線經測試,確保不會抑制微生物生長。
* 每個 3.1 mm 的方格代表 47 mm 直徑濾膜(總面積 9.6 cm²)過濾面積的 1/100。
2. 包裝便利:
* 提供獨立包裝,確保最佳無菌狀態。
3. 專為微生物測試而設計,並通過嚴格測試:
* 0.45 微米白色有格濾膜:經測試適用於 大腸菌群、糞便鏈球菌 及 紅色沙雷氏菌 (Serratia marcescens)。
* 0.65 微米白色有格濾膜:適用於完全截留與最佳回收 糞便性大腸菌群 和 釀酒酵母 (Saccharomyces cerevisiae)。
* 黑色與綠色濾膜:專為酵母菌與總細菌數的最佳回收率而設。
* 所有濾膜均經以下測試:
1. 濕潤性一致性
2. 格線不抑制微生物生長
3.在對應培養基上的顏色反應最佳化
►規格和訂購訊息
47mm(毫米)格狀無菌薄膜(100/包)

►應用:適用於在水和廢水行業中使用MF技術取得和培養微生物。